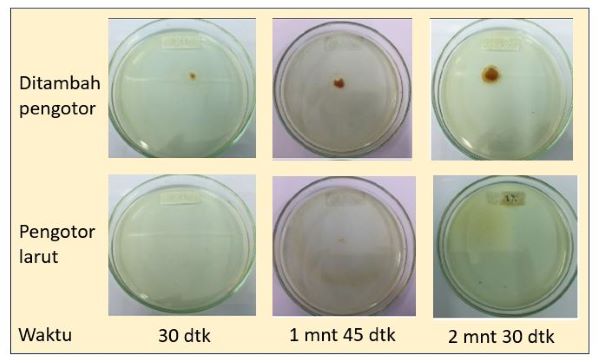

Biofuel atau biodiesel sebagai alternatif bahan bakar fosil yang dapat diandalkan telah memiliki peran strategis karena memberi pengaruh positif dalam berbagai aspek. Biofuel yang dihasilkan dari sumber terbarukan memberikan nilai tambah melalui hilirisasi industri pertanian dalam negeri, menstabilkan harga Crude Palm Oil (CPO) dan meningkatkan kesejahteraan petani kecil.
Selain itu, biofuel menghasilkan lebih sedikit emisi gas rumah kaca dibanding bahan bakar fosil, mengurangi bahan bakar impor, menghemat devisa negara dan neraca perdagangan, menyediakan kesempatan kerja, serta untuk menjaga ketahanan energi.
Pengembangan biofuel atau biodiesel atau juga disebut dengan biosolar tidak akan berhenti pada B35 saja, karena kementerian ESDM berencana untuk menaikkan tingkat pencampuran pada tahun mendatang. Saat ini kajian komprehensif sedang dilakukan, antara lain menyiapkan kajian tekno ekonomi, kerangka regulasi, fasilitas insentif, infrastruktur, penetapan standar kualitas produk serta pengembangan industri pendukung.
Penerapan kewajiban menggunakan biofuel yang melibatkan multi-stakeholder bukan tanpa tantangan. Salah satu tantangan terbesarnya adalah kandungan partikel pengotor yang terdapat di dalamnya, akibat sifat biodiesel yang mudah teroksidasi dan dapat menyebabkan timbulnya gel atau slime.
PT Eonchemicals Putra yang merupakan perusahaan specialty chemical mengembangkan fuel additive dengan merk EonFuel 708 untuk menjawab tantangan dengan memberikan solusi pada masalah biofuel tersebut.
Fuel additive EonFuel 708 mampu menurunkan jumlah partikel pengotor yang terkandung dalam biodiesel B35, karena memiliki kemampuan mendispersi (memecah) partikel pengotor menjadi bagian terkecil yang terbentuk dan terkandung pada biodiesel B35. Kemampuan ini bertujuan untuk menaikkan tingkat kebersihan biodiesel B35. Hal ini tentu memberikan efek postif pada filter (mengurangi blocking filter), fuel system dan membersihkan ruang bakar pada mesin diesel saat digunakan.
Proses Dispersi Pengotor
Berikut adalah ilustrasi proses dispersi pada biodiesel secara sederhana agar lebih mudah dipahami.
Bayangkan Anda memiliki segenggam pasir kasar. Pasir ini seperti partikel kotoran yang ada dalam biofuel, bahan bakar untuk mesin. Anda ingin membuat pasir ini menjadi halus agar tidak mengganggu mesin saat bekerja.
Sekarang, bayangkan Anda memiliki formula ajaib dalam bentuk cairan yang bisa membantu memecah pasir kasar ini menjadi butiran yang sangat halus. Saat formula ajaib dituangkan ke biofuel, pasir yang berada di dalamnya pecah menjadi butiran yang sangat kecil.
Ketika pasir kasar sudah menjadi butiran halus, maka tidak lagi mengganggu mesin. Proses memecah partikel kotoran ini disebut dispersi, dan itulah yang dilakukan fuel additive EonFuel 708 dalam biodiesel. Formula ini membuat semua pengotor menjadi halus dan bersih sehingga mesin bisa berjalan dengan baik.
Untuk menambah referensi, silakan simak penjelasan tentang fuel biocide yang juga sangat berguna untuk menjaga performa pemakaian biosolar.
Di bawah ini adalah foto hasil lab test pengotor biodiesel B35 atau yang sering dikenal dengan monogilesrida ketika diteteskan ke dalam biofuel yang telah ditambahkan fuel additive EonFuel 708.
Penggunaan EonFuel 708 merupakan solusi untuk memastikan bahwa biofuel B35 memenuhi atau bahkan melampaui standar kebersihan yang ditetapkan oleh ISO 4406, yang merupakan indikator penting untuk kinerja dan keandalan bahan bakar dalam aplikasi mesin diesel.

Data di atas adalah hasil uji cleanliness biodiesel setelah aplikasi EonFuel 708 di salah satu customer Eonchemicals, berhasil menurunkan partikel pengotor hingga 76%.
Silakan chat whatsapp untuk konsultasi atau mendapatkan keterangan tentang biofuel additive lebih detail.
Konsultasi dengan EON Sekarang
Kami siap mendengar dan memberikan solusi chemicals yang tepat untuk Anda. Konsultasi bersama pakar kami gratis!
